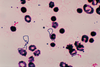

Infection Flashcards
(98 cards)
Neisseria Meningitidis
Mechanism of action?
- Direct contact with respiratory secretions
Neisseria Meningitidis
Interaction with host?
- Lives in the Naso/oropharynx
- Colonises and attacks the meninges of the brain
- Spreads to blood and causes a non-blanching rash
- Sereve immune reaction due to endotoxins
- Leads to septic shock, multi organ failure and death
Neisseria Meninigitidis
Gram Positive or Negative?
- Gram Negative

Neisseria Meningitidis
How would you diagnose?
- History
- Sudden onset, neck pain, fever, photophobia, nausea, malaise, abdomen pain, head ache, non blanching rash
- Several days of illness, gets worse before better due to endotoxin
- Examination
- Raised temperature, tachometer, tachocardia, low BP, pale and cold extremities
Neisseria Meningitidis
Possible sequalae?
- Septic shock and death
- Respiratory failure, kidney failure, raised ICP, coma and death
- Hearing loss, Ischemia and necrosis
Neisseria Meningitidis
Treatment and Prevention?
- Supportive
- High flow O2
- Adrenaline
- IV
- Measure urine output and lactate
- Analgesia
- Specific
- Blood cultures and blood spectrum antibiotics
- Ceftriaxone
- Prevention
- Vaccine, stay away from people with Meningitis
Escherichia Coli
Is it Gram Positive or Negative?
- Gram Negative

Escherichia Coli
Interaction with host?
- Colonise GI tract
- Gastroenteritis
- Peritonitis
- Infectio by ingestion of contaminated food or directly from a perforated bowel
Escherichia Coli
How would you diagnose?
- History
- Nausea, Vomiting, Fever, Malaise, Muscle weakness, Stomach cramps, chills
- Usually lasts a few days - resolves itself
- Examination
- Tender abdomen, raised temperature, BP, HR and respiratory changes
Escherichia Coli
Possible sequalae?
- Peritonitis, Septic shock and death
- Usually resolves
Escherichia Coli
Treatment and Prevention?
- Supportive
- IV, fluids and O2
- Specific
- Broad spectrum antibiotics
- Source control for peritonitis
- Prevention
- Disinfect food prep areas
- Do not share belonginings with others who have gastroenteritis
Staph Aureus
Is it Gram Positive or Negative?
- Gram Positive

Staph Aureus
Mechanism of infection?
- Invasion
- Inhalation
- Ingestion
Staph Aureus
Interaction with host?
- Coagulase- converts fibrinogen to fibrin forming microclot to protect itself
- Hyaluronidase- breaks down hyaluronidase acid in connective tissue so can break down barriers and spread
- DNA Ribonuclease- Breaks down host DNA
Staph Aureus
How to diagnose?
- Skin lesions
- If leads to sepsis will have tachycardia and hypotension
- Lasts a few days to weeks depending on severity of abscess
Staph Aureus
Possible Sequalae?
- Chronic abscess formation
- Scar tissue
- Resolution
- Sepsis
Staph Aureus
Treatment and Prevention?
- If sepsis then septic 6
- antibiotics
- Drain Abscess
- Hand washing tenchique and decontamination of cooking surfaces
Staph Epidermis
Is it Gram Positive or Gram Negative?
- Gram Positive

Staph Epidermis
Mechanism of infection?
- Inoculation onto prosthetic surfaces during surgery
Staph Epidermis
Interaction with host?
- Usually part of normal flora
- Biofilms on surgical equiptment cause local infections
- If sheared off can cause sepsis and shock
- Can cause rejection of prothetics
Staph Epidermis
How to diagnose?
- History
- Pain in the site of implant
- unsteadiness on affected joint
- Tenderness at the site of infection
- Joint dysfunction until new prosthetic
- Examination
- malaise
- fever
- myalgia
- reduced power in limbs
Staph Epidermis
Possible sequalae?
- Septicemia
- Septic shock
- Death
Staph Epidermis
Treatment and Prevention?
- Manage fever
- physiotherapist
- Replace prosthetic joint
- Surgical explore and removal
- Antibiotic
- Silver coated IV line as has an antibacterial agent, sterile surgical environment and antibiotic prophylaxis
Streptoccus Pneumoniae
Mechanism of infection?
- Direct contact
- Normal flora of upper respiratory tract
- Can colonise in lungs